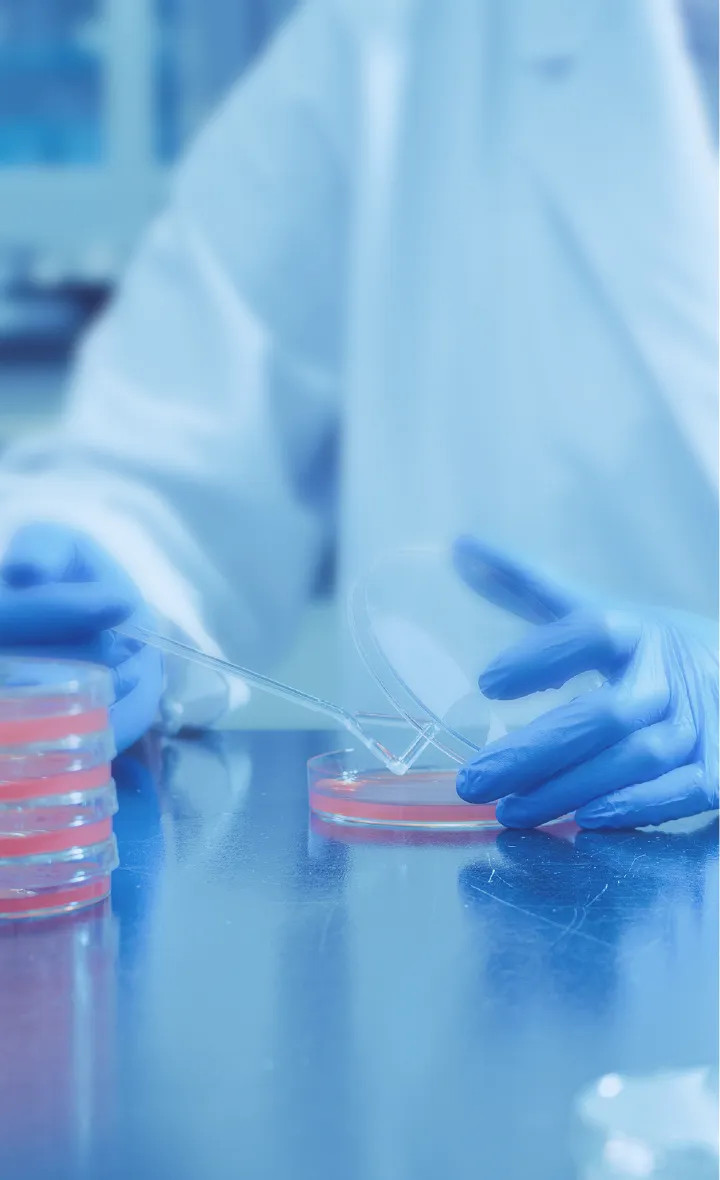
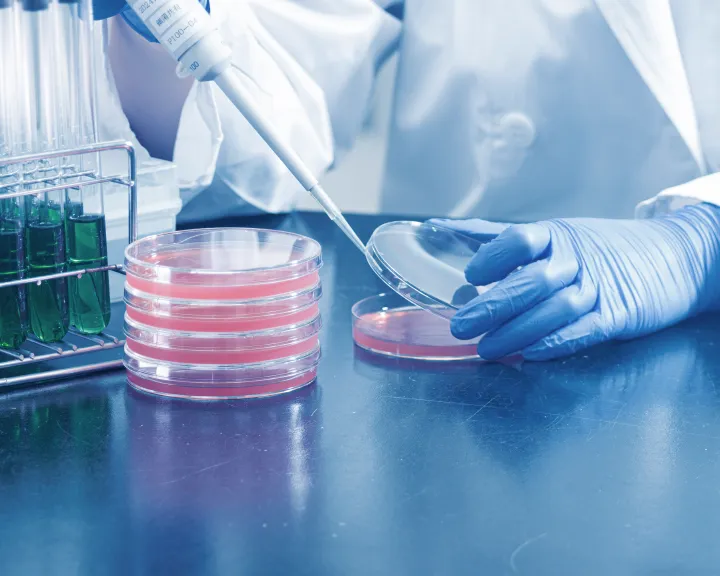

私たちについて
ABOUT US50年かけて熊本で育んだ信頼。
それが私たちの原点です。

私たちの礎は、1972年に設立された熊本県薬剤師会医薬品検査センターです。地域の暮らしに寄り添い、公衆衛生の向上に貢献してきた50年の歴史。そこで培われた実績と信頼こそが、私たちの最大の資産です。この揺るぎない土台の上に、再春館グループとして新たな技術を取り入れ、より広く、深く、社会の「安心・安全」に応えて参ります。
信頼に応える技術と設備
「安心して任せたい」——
その期待に、確かな品質で応えます。
ISO/IEC 17025 認定
認定範囲:「食品・医薬品試験」
試験分野:化学的試験
試験品目:農産物種類 野菜(トマト)
試験成分:農薬類「1.チアクロプリド、2.チアメトキサム、3.クロマフェノジド」
適用される方法:QuEChERS法を一部変更したLC/MS-MSによる試験法「農薬等の一斉試験法(農産物、加工品)」
多分野にわたる信頼の
公的認証
水道法第20条水質検査登録機関をはじめ、医薬品、残留農薬から作業環境まで。多岐にわたる分野の公的登録機関として、確かな検査をお届けします。
最新鋭の検査機器
高度な分析を可能にする最新設備で、多様なニーズにお応えします。
豊富な実績と信頼
20,000件/年(※1)を超える検査実績と延べ3,700社以上(※2)の取引社数
(※1)2025年度 (※2)2014年度-2025年度
ご依頼の流れ
お問合せ
お電話・フォームから
ご相談ください。
ご相談・お見積り
専門スタッフが最適な
検査を提案します。
検体の収集・採取
収集または出張採取を
行っております。
ご送付でも対応いたします。
検査・分析
最新設備で迅速・正確に
検査します。
結果ご報告
証明書を発行し、
結果をご報告します。
よくあるご質問
- 検査にはどのくらいの期間がかかりますか?
- 検査項目により異なりますが、通常は検体受領後5〜10営業日程度でご報告いたします。お急ぎの場合はご相談ください。
- 個人でも検査を依頼できますか?
- はい、個人のお客様からのご依頼も承っております。井戸水の検査など、お気軽にお問い合わせください。
- 検査結果の証明書は発行されますか?
- はい、すべての検査において、公的機関に提出可能な証明書を発行いたします。
検査・分析事例

大手食品メーカー様
HACCP導入支援と定期的な微生物検査により、食品衛生レベルが向上。クレーム件数が前年比80%減を達成。

宿泊施設様
温泉・浴槽水のレジオネラ属菌検査を定期実施。お客様に「安心の湯」としてPRでき、満足度向上に貢献。

化学工場様
作業環境測定と改善提案により、労働安全衛生法に基づく基準をクリア。従業員の職場環境改善を実現。
採用情報